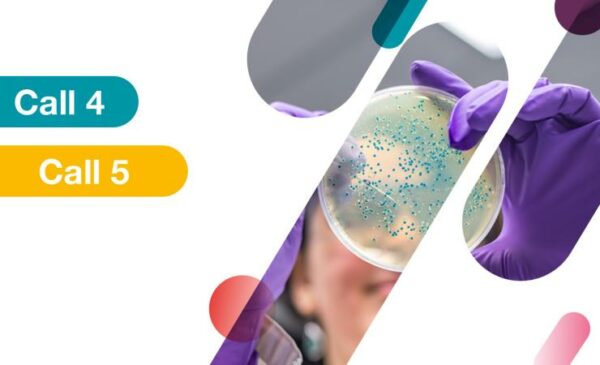
Banner Call4-5 (without logo)

The Innovative Health Initiative (IHI) launches the IHI – call 6 and IHI – call 7.
The Innovative Health Initiative (IHI) has now launched IHI – call 6 and IHI – call 7. IHI – call 6IHI – call 6 is a two-stage call for proposals with the following topics: Topic 1: Support healthcare system resilience through a focus on persistency in the treatment of chronic diseases Topic 2: Development of…